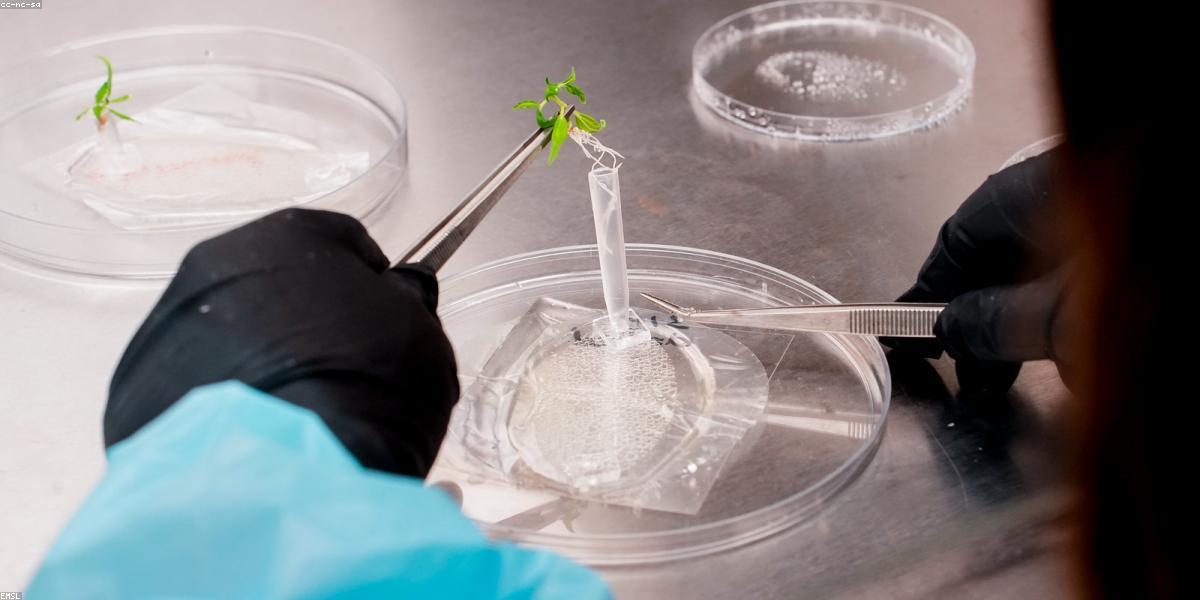
Không gian văn phòng xanh hiện đại 2024

Xu hướng cây cảnh văn phòng 2024: Top 5 loại cây đang "gây bão" tại PlantersParadise
Ngày đăng: 24/05/2024 | Danh mục: Tin tức xu hướng
Trong những năm gần đây, khái niệm "Biophilic Design" (Thiết kế xanh) không còn là một thuật ngữ xa lạ đối với giới kiến trúc và quản trị nhân sự. Bước sang năm 2024, việc đưa thiên nhiên vào không gian làm việc đã nâng tầm từ một sở thích cá nhân thành một chiến lược tối ưu hóa hiệu suất làm việc và cải thiện sức khỏe tinh thần cho nhân viên. Tại PlantersParadise, chúng tôi ghi nhận một sự chuyển dịch mạnh mẽ trong tư duy lựa chọn cây cảnh văn phòng: Không chỉ đẹp, mà còn phải mang tính biểu tượng, dễ chăm sóc và có khả năng lọc không khí vượt trội.
Tại sao cây cảnh văn phòng lại trở thành "cơn sốt" trong năm 2024?
Sự bùng nổ của xu hướng cây cảnh văn phòng năm nay không chỉ đến từ yếu tố thẩm mỹ. Theo các nghiên cứu về tâm lý học hành vi, sự hiện diện của mảng xanh trong không gian kín giúp giảm tới 37% mức độ căng thẳng và lo âu. Trong bối cảnh áp lực công việc ngày càng tăng, các doanh nghiệp đang tìm kiếm những giải pháp "mềm" để giữ chân nhân tài và tạo ra môi trường làm việc đầy cảm hứng.
Tại PlantersParadise, chúng tôi nhận thấy khách hàng không còn ưu tiên những chậu cây nhỏ đặt bàn đại trà. Thay vào đó, xu hướng năm nay tập trung vào những loại cây có cấu trúc lá độc đáo, mang đậm tính nghệ thuật và có khả năng tạo ra những "điểm nhấn xanh" (Green Focal Points) trong các văn phòng mở (Open Office).
Top 5 loại cây cảnh văn phòng đang dẫn đầu xu hướng tại PlantersParadise
1. Monstera Deliciosa (Trầu bà lá xẻ Nam Mỹ) - "Nữ hoàng" của sự sang trọng
Vẫn giữ vững ngôi vương từ những năm trước, nhưng năm 2024, Monstera Deliciosa được ưa chuộng ở những kích thước lớn hơn để đặt tại các khu vực sảnh chờ hoặc phòng họp lớn. Với những chiếc lá to bản có những đường xẻ tự nhiên tinh tế, Monstera không chỉ mang lại vẻ đẹp nhiệt đới mà còn là biểu tượng của sự thăng tiến và sức sống mãnh liệt.
Tại PlantersParadise, dòng Monstera được chăm sóc kỹ lưỡng để đảm bảo độ bóng mượt của lá và sự chắc khỏe của thân cây, phù hợp với môi trường điều hòa khắc nghiệt của văn phòng.

2. Sansevieria (Lưỡi hổ) - "Máy lọc không khí" bền bỉ nhất
Không có gì ngạc nhiên khi Lưỡi hổ luôn nằm trong danh sách bán chạy nhất. Năm 2024, các dòng Lưỡi hổ Thái hoặc Lưỡi hổ vàng với kiểu dáng gọn gàng, cứng cáp đang được các startup công nghệ đặc biệt ưa chuộng. Đặc tính sản sinh oxy vào ban đêm và khả năng lọc bỏ các độc tố như formaldehyde hay benzene khiến nó trở thành người bạn đồng hành lý tưởng trong các văn phòng nhiều thiết bị điện tử.
3. Ficus Lyrata (Bàng Singapore) - Điểm nhấn kiến trúc tối giản
Nếu văn phòng của bạn theo đuổi phong cách Scandinavian hoặc Minimalism, Bàng Singapore chính là lựa chọn không thể bỏ qua. Với thân cây thẳng tắp và những chiếc lá xanh thẫm hình chiếc đàn cầm, loại cây này tạo nên một cấu trúc không gian rõ rệt. Nó tượng trưng cho sự chính trực và vững vàng, rất phù hợp để đặt cạnh bàn làm việc của các cấp quản lý.

4. Zamioculcas Zamiifolia (Cây Kim tiền) - Biểu tượng của tài lộc và may mắn
Trong văn hóa kinh doanh Á Đông, cây Kim tiền luôn chiếm một vị trí đặc biệt. Những lá cây mọc đối xứng, xanh mướt hướng lên trên tượng trưng cho sự đi lên không ngừng của doanh nghiệp. Điểm mạnh nhất của Kim tiền tại PlantersParadise chính là khả năng chịu hạn cực tốt, rất phù hợp với những nhân viên bận rộn đôi khi quên tưới nước cho cây.
5. Strelitzia Reginae (Cây Thiên điểu) - Mang hơi thở nhiệt đới vào văn phòng
Một tân binh đang "gây bão" trong danh mục Tin tức xu hướng của chúng tôi chính là cây Thiên điểu. Với những chiếc lá vươn cao mạnh mẽ, Thiên điểu tạo ra một cảm giác tự do và phóng khoáng. Loại cây này thường được sử dụng để phân chia không gian giữa các phòng ban một cách tự nhiên mà không cần đến những vách ngăn khô cứng.

Làm thế nào để chọn cây cảnh phù hợp cho văn phòng của bạn?
Việc lựa chọn cây cảnh không chỉ dừng lại ở sở thích, mà cần dựa trên các yếu tố thực tế tại môi trường làm việc. PlantersParadise xin chia sẻ một số bí quyết giúp bạn chọn được "người bạn xanh" ưng ý:
- Cường độ ánh sáng: Hãy xác định vị trí đặt cây có bao nhiêu ánh sáng tự nhiên. Nếu văn phòng chỉ có ánh sáng đèn huỳnh quang, Lưỡi hổ hoặc Kim tiền sẽ là lựa chọn an toàn nhất.
- Diện tích không gian: Với những góc nhỏ, hãy chọn các loại cây phát triển theo chiều dọc như Bàng Singapore. Với không gian rộng, đừng ngần ngại chọn Monstera để tạo sự lấp đầy thẩm mỹ.
- Khả năng chăm sóc: Nếu công ty không có đội ngũ chăm sóc cây chuyên nghiệp, hãy ưu tiên những loại cây cần ít nước và có sức sống bền bỉ.
Dịch vụ setup cây cảnh trọn gói tại PlantersParadise
Tại PlantersParadise, chúng tôi không chỉ bán cây, chúng tôi cung cấp giải pháp không gian sống xanh. Hiểu được nỗi lo của khách hàng về việc cây bị héo úa sau một thời gian đặt tại văn phòng, chúng tôi đã phát triển gói dịch vụ chăm sóc định kỳ chuyên nghiệp. Đội ngũ chuyên gia của chúng tôi sẽ đến tận nơi để kiểm tra độ ẩm, bón phân và vệ sinh lá cây, đảm bảo mảng xanh của bạn luôn trong trạng thái hoàn hảo nhất.
Năm 2024 cũng là năm PlantersParadise đẩy mạnh việc kết hợp các loại chậu gốm thủ công nghệ thuật với cây cảnh, giúp mỗi chậu cây trở thành một tác phẩm decor thực thụ, phản ánh cá tính và thương hiệu của doanh nghiệp.

Lời kết
Đầu tư vào cây cảnh văn phòng là khoản đầu tư thông minh cho cả sức khỏe và hiệu suất công việc. Với danh sách Top 5 loại cây đang dẫn đầu xu hướng 2024 trên đây, hy vọng bạn đã có thêm ý tưởng để làm mới không gian làm việc của mình. Hãy để PlantersParadise giúp bạn biến văn phòng khô khan thành một thiên đường xanh đầy cảm hứng.
Liên hệ ngay với chúng tôi để nhận được tư vấn miễn phí về thiết kế không gian xanh cho văn phòng của bạn trong năm 2024 này!
